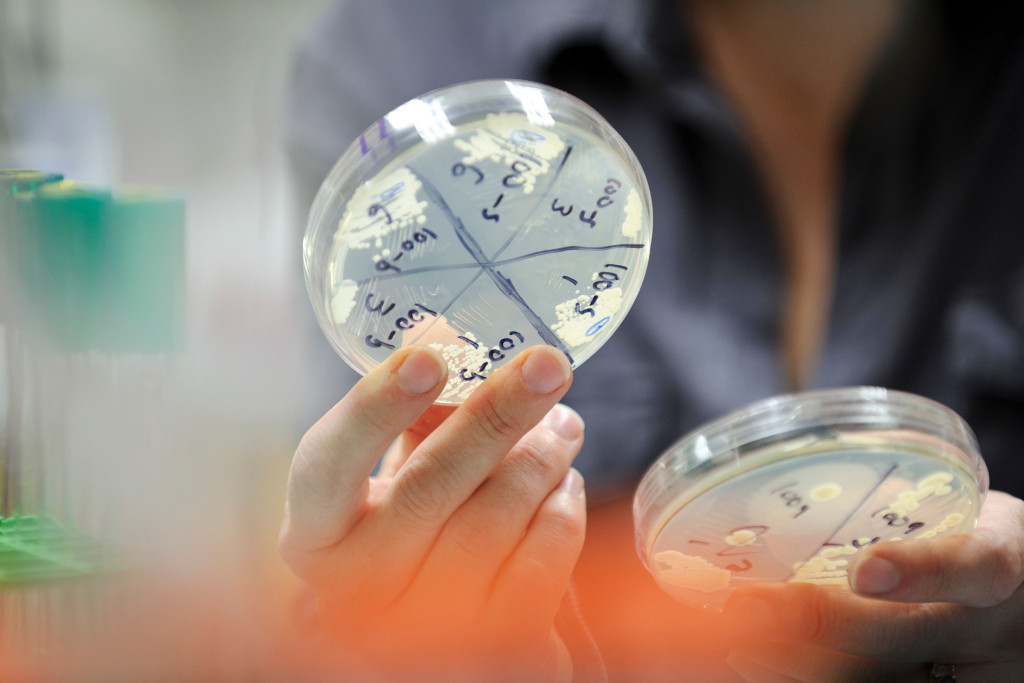
UWFlow's tweet card. Badger-led research strengthens communities, saves lives, and supports thousands of jobs. Learn why this work matters—and how you can support it.

UW Flow Cytometry
@UWFlow
The UW Flow Cytometry Lab provides cutting-edge instrumentation, technical expertise, and education for fluorescence based single cell analysis and isolation.
You might like
47th Annual Course in Cytometry! June 8-13, 2024 at the University of Wisconsin - Madison. Keynote Speaker: Jonathan Irish. Hands-on Labs & Lectures. Registration open through June 2: conferences.union.wisc.edu/flowcytometry/ #flwocytometry

Seminar: Image enabled cell sorting using the BD FACSDiscover(TM) S8, 11am, Sept 14, 2023, WIMR 5001A. tinyurl.com/yjmb9s5a

We are proud to continue our 50-year tradition as Wisconsin’s only National Cancer Institute (NCI)-designated comprehensive cancer center. We received an outstanding-level grade during our most recent NCI review. uw.health/3HbdFyW

Submit your Oral and Poster Abstracts for a chance to present at CYTO 2023. Deadline: January 13, 2023. Learn more: cytoconference.org/abstracts.html #CYTO2023, #Cytometry, #ISAC_CYTO
Interested in #FlowCytometry data analysis with #Rstats/ @Bioconductor ? Have a look at our course, in which participants will be introduced to what flow cytometry is and why we use it to analyze cell population composition in biological samples 🔗physalia-courses.org/courses-worksh…

Join us on October 12, 2022, for “Radioactivity and Flow Cytometry”, presented by Dagna Sheerar & Kathryn Fox. Discounted registration for Silver and Bronze ISAC members and FREE for Platinum and Gold members. Join today! #CytoU learning.isac-net.org/products/radio…

From @WSJ Wall Street Journal: Photos & Videos on using environmental DNA (e-DNA) to search for remains of missing sailors & aviators lost at sea. Features a quote from Charles Konsitzke of @UWMadison @UWBiotechCente1 @UWMIARIP @wsst @wisconsin4h wsj.com/story/how-edna…
Found some reading for the plane on the way to #CYTO2022: onlinelibrary.wiley.com/doi/full/10.10…
We can't wait to check out “Environmental Cytometry" June 7th 13:30-15:00, presented by David Galbraith, Ph.D. - Professor in the University of Arizona School of Plant Sciences, Arizona Cancer Center and Heidi Sosik, Ph.D. - Senior Scientist, Woods Hole Oceanographic Institution.

I'm going to FRONTIERS IN FLOW CYTOMETRY™. Who's joining me? events.bizzabo.com/FrontiersInFlo…
Where are allosteric hotspots located in a protein? What properties differentiate such hotspots from other residues? We combine deep mutational scanning of four homologs with machine learning to reveal molecular rules governing allosteric hotspots. biorxiv.org/content/10.110…
Just bought my ISAC T-Shirt to support Student and SRL Travel Awards! Get your's here: bit.ly/3KNMudj

Still space available for the 45th Annual Course in Cytometry, June 18-23, 2022. Keynote Speaker: John Nolan! Final Agenda & Registration here: conferences.union.wisc.edu/flowcytometry/

United States Trends
- 1. #WWERaw 62K posts
- 2. Purdy 25.8K posts
- 3. Panthers 35.2K posts
- 4. Bryce 19.2K posts
- 5. 49ers 36.9K posts
- 6. Canales 12.9K posts
- 7. #FTTB 5,247 posts
- 8. Mac Jones 4,708 posts
- 9. Penta 9,485 posts
- 10. #KeepPounding 5,204 posts
- 11. Niners 5,315 posts
- 12. Gunther 13.8K posts
- 13. Jaycee Horn 2,615 posts
- 14. Jennings 8,079 posts
- 15. #RawOnNetflix 2,078 posts
- 16. TMac 1,444 posts
- 17. Ji'Ayir Brown 1,254 posts
- 18. Moehrig N/A
- 19. Melo 18.4K posts
- 20. Rico Dowdle 1,617 posts
Something went wrong.
Something went wrong.